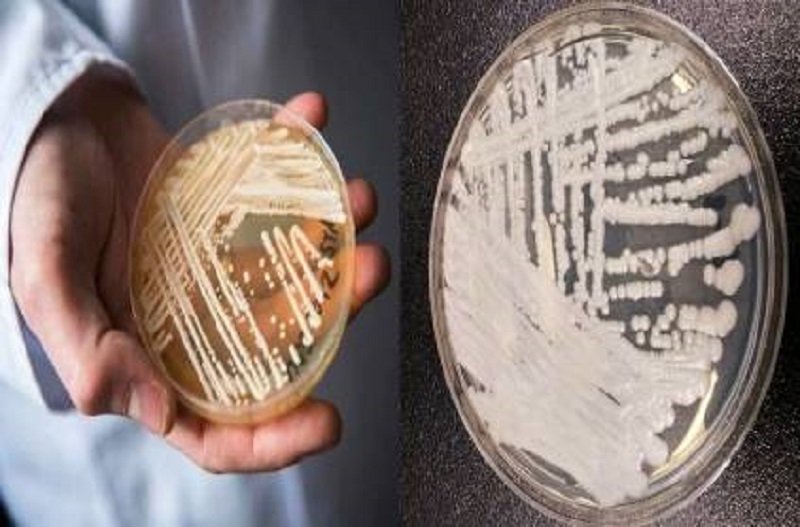

இன்னும் கொரோனா வைரஸ் தாக்கமே குறையாத நேரத்தில் அமெரிக்காவில் புதிய பூஞ்சை தொற்று பரவி உயிருக்கு ஆபத்தான நோயாக உருமாறி வருகிறது.+
அமெரிக்காவின் சில பகுதிகளில் புதிதாக கேண்டிடா என்ற ஆரிஸ் என்ற ஒரு வகை பூஞ்சை நோய் மக்களிடையே பரவி வருகிறது.
புதிதாக பரவி வரு இந்த பூஞ்சை நோயால் பாதிக்கப்பட்ட மக்களுக்கு சிகிச்சையளிப்பது சிரமமாக இருப்பதாக அமெரிக்க சுகாதார அதிகாரிகள் தெரிவித்துள்ளனர்.
இந்த பூஞ்சை தொற்று மனிதர்களுக்கு பரவிய சில மணி நேரத்தில் ரத்த ஓட்டத்தை பாதித்து மரணத்தை ஏற்படுத்தும் அளவுக்கு ஆபத்தானதாக இருப்பதாகவும் அமெரிக்க சுகாதாரத்துறை கூறியுள்ளது.
இதுவரை வாஷிங்டனில் 101 பேருக்கும், டல்லாஸ் மருத்துவமனைகளில் 22 பேருக்கும் கேண்டிடா ஆரிஸ் தொற்று உள்ளது உறுதிசெய்யப்பட்டுள்ளது.
கேண்டிடா என்ற ஆரிஸ் நோய் தொற்று ஏற்பட்டோருக்கு காய்ச்சல் மற்றும் குளிர் உணர்வு ஏற்படுவது பொதுவான அறிகுறிகளாக இருப்பதாக மருத்துவர்கள் தெரிவித்துள்ளனர். அதோடு நோயாளிகளுக்கு சிகிச்சையின் போது ஆன்டிபயாடிக் சிகிச்சை அளிக்கபட்டால் கூட உடல்நிலையில் எந்தவித மாற்றமும் ஏற்படவில்லை என அமெரிக்க நோய் கட்டுப்பாடு மற்றும் தடுப்பு மையங்கள் தெரிவித்துள்ளன.
இந்த புதுவித கேண்டிடா ஆரிஸ் பூஞ்சை நோய் கடந்த வியாழக்கிழமை டல்லாஸ் பகுதி மற்றும் வாஷிங்டன் டி.சி.யில் உள்ள மருத்துவமனையில் முதலாவதாக அறியப்பட்டுள்ளதும் குறிப்பிடத்தக்கது.